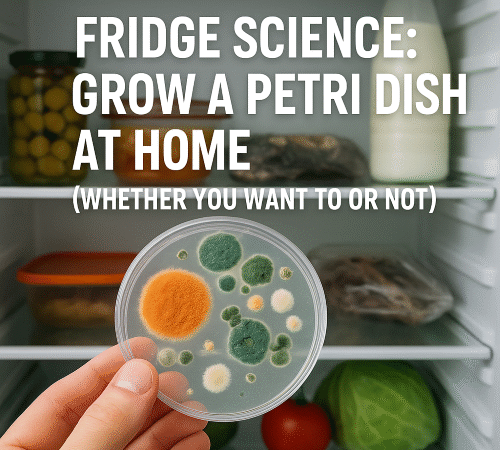
Fridge Science: Grow a Petri Dish at Home (Whether You Want To or Not)

What Not to Do in a Job Interview (If You Don’t Want the Job)
- 11 months ago
- Estimated read time 4 min read
So you’ve landed a job interview. Congratulations! Time to blow it spectacularly. Whether you’re plotting your escape from corporate drudgery or just conducting social experiments with HR personnel, here’s your foolproof guide to making sure you never get a callback. Of course, if you do want the job, simply do…
The 5 Most Useless Forms of Self-Care
- 12 months ago
- Estimated read time 4 min read
Because You Can’t Namaste Your Way Out of Burnout Self-care. The glittering buzzword of our overstimulated, overcaffeinated, productivity-addicted era. Once upon a time, it meant eating vegetables and getting 8 hours of sleep. Now it’s evolved into a chaotic circus of jade eggs, 27-step skincare routines, and breathwork sessions that…
How to Guarantee You’re Stressed All the Time
- 2 years ago
- Estimated read time 3 min read
We’ve all heard about the importance of managing stress, but what if you’re not trying to manage it? What if you’re an overachiever who wants to be perpetually on edge? If you’re a go-getter who’s not content unless they’re feeling the burn of a tight deadline or the weight of…
The 5 Worst Things You Can Do to Ruin a Good Night’s Sleep (And How to Fix Them)
- 2 years ago
- Estimated read time 3 min read
We all know the glorious feeling of waking up well-rested, refreshed, and ready to take on the world. Unfortunately, most of us also know what it’s like to toss and turn at 3 a.m., replaying awkward conversations from 2007 or doom-scrolling our way into insomnia. If you’ve ever wondered why…
How to Make Your Life More Complicated, Not Less
- 2 years ago
- Estimated read time 5 min read
A satirical guide to terrible lifehacks and the subtle art of wasting your own time Are you tired of things being too easy? Do you wake up some days thinking, “Wow, life is running so smoothly—I miss chaos”? Well, you’re in luck. We’ve compiled the ultimate anti-lifehacking guide to ensure…
5 Ways to Ensure Your Cocktails Will Be Completely Undrinkable 🍹
- 2 years ago
- Estimated read time 4 min read
A guide to bartending blunders so catastrophic, they’ll have your guests begging for water. Whether you’re hosting a house party or just trying to impress your date with a “simple” Negroni, there’s one universal truth in home mixology: it’s far easier to screw up a cocktail than to get it…